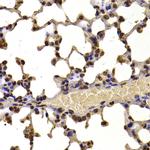
NSD2 Antibody in Immunohistochemistry (Paraffin) (IHC (P))

Search
Invitrogen
NSD2 Polyclonal Antibody
{{$productOrderCtrl.translations['antibody.pdp.commerceCard.promotion.promotions']}}
{{$productOrderCtrl.translations['antibody.pdp.commerceCard.promotion.viewpromo']}}
{{$productOrderCtrl.translations['antibody.pdp.commerceCard.promotion.promocode']}}: {{promo.promoCode}} {{promo.promoTitle}} {{promo.promoDescription}}. {{$productOrderCtrl.translations['antibody.pdp.commerceCard.promotion.learnmore']}}
图: 1 / 3
NSD2 Antibody (PA5-96870) in IHC (P)

Please note: We are reviewing Western blot images included in the antibody testing data in our catalog, including those provided by third parties. Unless expressly labeled or annotated as “raw-unedited”, Western blot images included in the antibody testing data in our catalog may have been edited, optimized or otherwise adjusted for presentation.
产品信息
PA5-96870
种属反应
宿主/亚型
分类
类型
抗原
偶联物
形式
浓度
规格
纯化类型
保存液
内含物
保存条件
运输条件
RRID
产品详细信息
Positive Samples: HeLa, HepG2, SW620, Mouse brain, Mouse spleen; Cellular Location: Chromosome, Cytoplasm, Nucleus
靶标信息
This gene encodes a protein that contains four domains present in other developmental proteins: a PWWP domain, an HMG box, a SET domain, and a PHD-type zinc finger. It is expressed ubiquitously in early development. Wolf-Hirschhorn syndrome (WHS) is a malformation syndrome associated with a hemizygous deletion of the distal short arm of chromosome 4. This gene maps to the 165 kb WHS critical region and has also been involved in the chromosomal translocation t(4;14)(p16.3;q32.3) in multiple myelomas. Alternative splicing of this gene results in multiple transcript variants encoding different isoforms. Some transcript variants are nonsense-mediated mRNA (NMD) decay candidates, hence not represented as reference sequences.
仅用于科研。不用于诊断过程。未经明确授权不得转售。
篇参考文献 (0)
生物信息学
蛋白别名: Histone-lysine N-methyltransferase NSD2; IL5 promoter REII region-binding protein; MMSET; Multiple myeloma SET domain-containing protein; Nuclear SET domain-containing protein 2; probable histone-lysine N-methyltransferase NSD2; trithorax/ash1-related protein 5; Wolf-Hirschhorn syndrome candidate 1 protein homolog
基因别名: 5830445G22Rik; 9430010A17Rik; AW555663; C130020C13Rik; D030027O06Rik; D930023B08Rik; Kiaa1090; mKIAA1090; MMSET; NSD2; Whsc1; Whsc1l
UniProt ID: (Mouse) Q8BVE8
Entrez Gene ID: (Mouse) 107823



